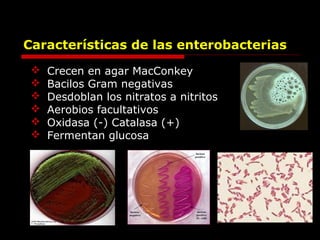

Este documento resume las pruebas bioquímicas utilizadas para identificar enterobacterias, incluyendo pruebas como TSI (Triple Sugar Iron), LIA (Lysine Iron Agar), citrato de Simmons, urea y MIO (Motilidad-Indol-Ornitina). Explica los principios, componentes y resultados esperados de cada prueba para ayudar en la identificación de géneros comunes de enterobacterias como Escherichia, Klebsiella y Proteus.